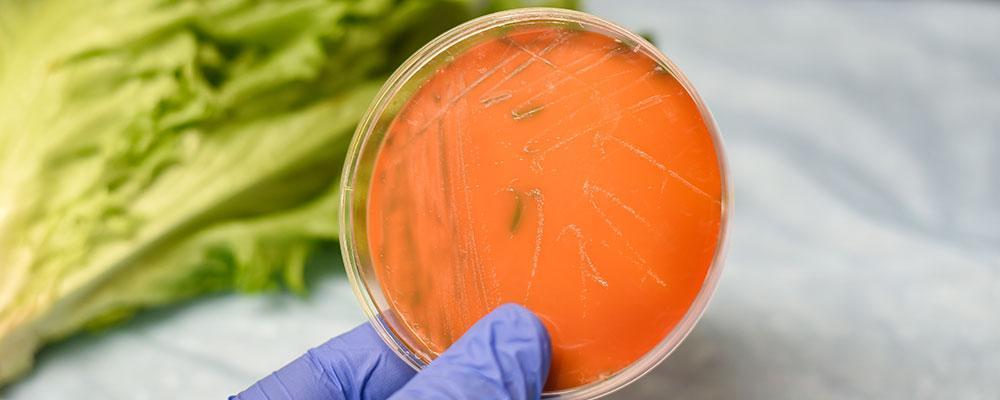
Chicago listeria poisoning attorney

312-981-0409
33 N Dearborn St 10th Floor, Chicago, IL 60602
Serving Clients Across 8 Illinois Locations
Illinois Listeria Food Poisoning Attorneys
Personal Injury Lawyers for Chicago Food Illness Victims
Listeria (also known as listeriosis) is a severe infection typically transmitted by contaminated food. While there are far fewer annual cases than E. coli, norovirus, salmonella, and other types of food poisoning, the fatalities ratio for listeria is extremely high. According to data from the Centers for Disease Control and Prevention (CDC), of an estimated 1,600 cases each year, around 260 are fatal, which means around 1 in 6 Americans infected by listeria dies as a result. Pregnant women and their newborn children, seniors, and those with weakened immune systems have a greater risk of severe infection.
Newland & Newland, LLP fights for the compensation food poisoning victims deserve. Previous settlements include $53,000 from a local restaurant chain that wanted to avoid bad publicity after our client was sickened and hospitalized for multiple days.
Listeria Symptoms
Symptoms of listeria include diarrhea and fever often associated with foodborne illnesses. Invasive listeriosis, however, spreads beyond the stomach, and effects differ between pregnant females and other infected persons:
Pregnant women: Symptoms may include fever, fatigue, and muscle aches. Infections can cause premature delivery, stillbirth, miscarriage, or life-threatening illness passed to a newborn.
Other infected individuals: Symptoms may include muscle aches, headaches, stiff neck, mental confusion, lost balance, and convulsions.
Victims of invasive listeriosis usually experience symptoms within one to four weeks after consuming contaminated food, but some cases have developed up to 70 days following initial exposure.
If you experience any combination of these symptoms, visit a doctor as soon as possible. Listeriosis can be diagnosed via lab test through a blood sample and is treated with antibiotics.
Causes of Listeria
Instances of listeria have dropped significantly since the 1990s when outbreaks caused by processed meats led to better safety measures. Still, the danger remains, and potential sources include:
- Raw milk;
- Soft cheeses, including queso fresco;
- Raw sprouts, including alfalfa, radish, clover, and mung bean;
- Melons, including cantaloupe;
- Smoked seafood; and
- Deli meats and hot dogs (cold, not cooked).
By seeing a physician for your symptoms quickly, you improve your chances of a full and timely recovery. This is extremely critical when it comes to listeria, which carries an increased risk of severe and even fatal outcomes. Also, you reduce the threat of a wide-scale outbreak, as once your doctor makes a diagnosis, they can inform local health authorities, who can then investigate to confirm the source.
Contact a Chicago Listeria Injury Attorney
Foodborne illness symptoms can range from stomach pain to total organ failure and death. Food poisoning outbreaks in the United States are common, including at grocery stores and food markets that sell contaminated food. If you contract listeria from tainted produce or meat, you could be entitled to financial compensation for medical bills and pain and suffering that result from your infection. For a free phone consultation with a skilled Illinois food poisoning lawyer from Newland & Newland, LLP, who can help secure the financial award you deserve, contact us today at 312-981-0409. We have five convenient locations throughout the Chicago area to serve you including Arlington Heights, Libertyville, Chicago, and Itasca.
-

Foreclosure and Bankruptcy
Visit Website -

Real Estate and Estate Planning
Visit Website -

Personal Injury
Visit Website

 Spanish
Spanish Cantonese
Cantonese















